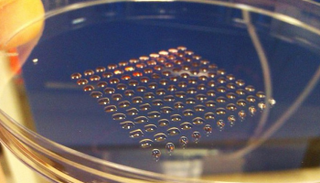
الخلايا الحية تقنية واعدة للبناء

حقل "جبل علي".. يحقق الاكتفاء الذاتي للإمارات من الغاز الطبيعي
الإمارات العربية المتحدة أعلنت اكتشاف حقل غاز جديد بين إمارتي أبوظبي ودبي باحتياطيات تبلغ 80 تريليون قدم مكعب.

الإمارات العربية المتحدة أعلنت اكتشاف حقل غاز جديد بين إمارتي أبوظبي ودبي باحتياطيات تبلغ 80 تريليون قدم مكعب.

العلماء يعتقدون أن تصنيف هذه الديناصورات يقع ما بين التماسيح والطيور الحديثة فيما يتعلق ببيولوجيا التكاثر

تاريخيا تم اختراع المنشار في الأساس لاستخدامه في عمليات الولادة الصعبة وليس للخشب واستمر طويلا لحين تطور العمليات القيصرية

علماء إسبان اكتشفوا فيلة قزمة بحجم الحمير الصغيرة من عصور ما قبل التاريخ كانت تجوب جزر البحر الأبيض المتوسط

باحثون صينيون استلهموا آلية عرق الثدييات لتنظيم حرارة الجسم في تطوير طلاء يسهم في خفض درجة حرارة الأجهزة الإلكترونية

باحثون فنلنديون طوّروا نظام حاسوب جديدا يمكنه التعرف على الأفراد من خلال مراقبتهم وهم يرقصون

شركة دينتكس قالت إنها فقدت طائرتها المزودة بمحرك توربيني بعد إطلاقها من على متن طائرة نقل عسكرية بنحو ساعة ونصف الساعة
المباني قد يمكنها امتصاص المواد الضارة من الهواء، وأن تضيء أو تتوهج بناء على طلب الساكن

فريق بحثي ياباني يطور طريقة جديدة للتحكم في الروبوتات من أجل تحسين قدرتها في مجال التمريض.
كانت هذه اخر صفحة
هناك خطأ في التحميل